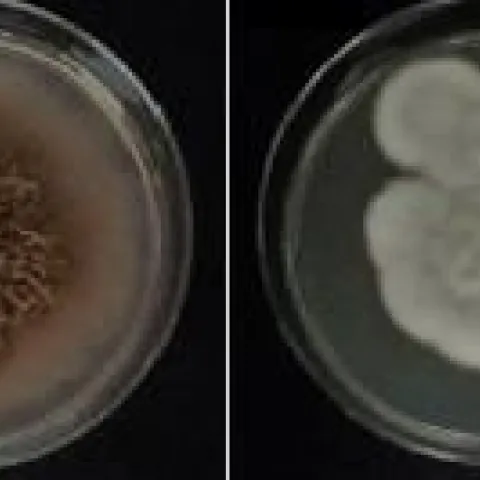
fungal mats

Topics in Subtropics

April 16 (1 -3 PM)
Water Knowledge is
Power Knowledge
In-Person and Zoom
Topics and Speakers
Sources of ET information and their Reliability
By Ali Montazar - UCCE Irrigation Advisor, Imperial/San Diego/ Riverside counties
Selecting Irrigation Emitters-Drip vs Microsprinkler
Stu Styles - Cal Poly SLO Irrigation Training and Education Center
We would love to meet you in person at
The San Diego County Farm Bureau (420 S Broadway, Escondido, CA 92025)
The San Diego County Farm Bureau (420 S Broadway, Escondido, CA 92025)
If you cannot attend the meeting, register through our Zoom link.